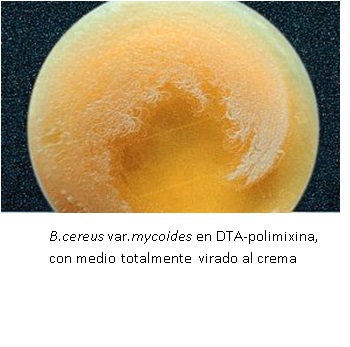

KIT DE CONFIRMACIÓN DE COLONIAS DE PRESUNTOS BACILLUS CEREUS
Confirmación Bacillus cereus en KIT, para alimentos, según ISO 7932. Incluye todo lo necesario para la confirmación de colonias sospechosas: M-IDENT®-Bacillus cereus
PARA USO EXCLUSIVO EN LABORATORIO MANTENGA LA CAJA CERRADA, EN LUGAR SECO, FRESCO Y OSCURO.
CODIGO: KMT009
VENTAJA: Su extremadamente larga caducidad, de 1 año asegurado.
PRESENTACION:
KIT DE 6 TEST para la confirmación de colonias sospechosas de Bacillus cereus:
– 6 tubos sólidos de color violeta de Agar DTA-Polimixina (TPL092)
– 6 tubos líquidos incoloros de MRVP (TPL025).
– 1 kit de reactivos de Voges Proskauer 1 + 2 de 5 ml cada uno, suficiente para las 6 pruebas (SRH083).
– 6 tubos semisólidos e incoloros de Medio Nitratos-Movilidad (TPL079).
– 1 kit de Reactivos de Nitratos A + B de 5 ml cada uno, suficiente para las 6 pruebas (SMN001).
EL KIT NO INCLUYE:
- Cepas de reserva, de trabajo o cuantitativas para validar los reactivos una vez llegados a fábrica o tras almacenamientos prolongados o inadecuados.
- Participación en servicios intercomparativos como SEILALIMENTOS para validar los procedimientos y los operarios
CONTROL DE CALIDAD DEL KIT
Realizado en nuestro laboratorio; es prudente repetirlo en su laboratorio siempre que varíen las condiciones (más de 3 meses sin usar, tras desinfectar laboratorio, tras conservar a alta Tª, cuando adquiere aspectos extraños aunque no haya llegado la fecha de caducidad teórica de la etiqueta,…)
TUBOS PREPARADOS DTA-polimixin Agar: Estéril, violeta-púrpura, sólido, inclinado.
Y TUBOS PREPARADOS MRVP Broth: Estéril, líquido, incoloro-paja.
TUBOS PREPARADOS Nitratos-Movilidad: Estéril, incoloro, semisólido.
KIT VP: NO estéril, goteros 1 + 2 con 5 ml cada uno. IRRITANTE.
KIT Nitratos: NO estéril, goteros 1 + 2 con 5 ml cada uno. IRRITANTE.
CONTROL DE CRECIMIENTO a 30°C durante 24 horas, en aerobiosis:
En el tubo violeta de DTA-polimixina, Bacillus cereus MKTA10876 crece con viraje del medio a amarillo-crema.
Y en el tubo líquido incoloro de MRVP Broth, Bacillus cereus MKTA10876 crece y tras añadir los reactivos VP vira a rosa.
En el tubo crema de Buffered Nitrate-Motility Medium, Bacillus cereus MKTA10876 crece con difusión/movilidad y reduce el nitrato a nitrito con viraje a rojo tras añadir los reactivos de Nitratos.
MODO DE EMPLEO E INTERPRETACIÓN DE RESULTADOS
Inocular una porción de colonia sospechosa pura, procedente, de B.cereus Agar Mossel, en estría en el tubo violeta de DTA-Polimixina; por dilución en el tubo de caldo MRVP y por picadura en el tubo semisólido crema de Buffered Nitrate-Motility Medium. Incubar los tres tubos a 30+2º C durante 21+3 horas, en condiciones aerobias. Observar el viraje a amarillo del DTA, el viraje a rosa de MRVP 1 hora después de añadir 0,5 ml de los reactivos VP, el viraje a rojo de los Nitratos 15 minutos después de añadir 0,5 ml de los reactivos de Nitratos, y la movilidad, positiva si hay crecimiento difuso desde la línea de picadura.
Bacillus cereus, según Norma ISO 7932:1998 adaptada, es toda colonia sospechosa procedente de Agar Mossel, que crece en DTA-polimixina con viraje del medio violeta a amarillo, que provoca test positivo de VP en MRVP (viraje a rosa), que provoca test positivo de Nitratos en el medio de Nitratos-Movilidad (viraje a rojo) y que crece difuso, por movilidad, a partir de la picadura en el medio de Nitratos-Movilidad.
NOTA:
La versión más moderna de esta Norma no habla de Bacillus cereus, sino de presuntos B.cereus, por lo que no la aplicamos.
Si desea más información sobre nuestros M-IDENT®-Bacillus cereus, rellene nuestro formulario de contacto http://www.medioscultivo.com/contacto . O si lo prefiere póngase en contacto con nosotros a través de nuestro correo electrónico microkit@microkit.es o por teléfono en el nº 91-897 46 16
https://www.microkit.es/fichas/Bacillus-cereus-M-IDENT-KIT-UE-2-2019-alimentos.pdf
https://www.microkit.es/monograficos/10-Bacillus-monograf–a.pdf